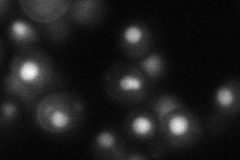
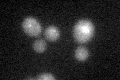
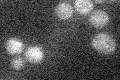

View description
Nucleosome assembly factor, involved in chromatin assembly and disassembly, anti-silencing protein that causes derepression of silent loci when overexpressed; plays a role in regulating Ty1 transposition
Localization:
Intensity:
Fold change:
Significance:
-
C’ GFP library in SD

below threshold15.84 -
N' NOP1pr-GFP in SD

nucleus121.767 -
N' TEF2pr-mCherry in SD

nucleus220.599 -
N' NATIVEpr-GFP in SD
nucleus45.3354 -
N' TEF2pr-VC and Cyto-VN in SD

#N/A0 -
C’ GFP library in SD+DTT
cytosol16.271.02No -
C’ GFP library in SD+H2O2

cytosol16.621.04No -
C’ GFP library in Starvation Media
cytosol15.120.95No -
C’ GFP library on the background of Pup2-DaMP

below threshold -
C’ GFP library on the background of CCT mutant

below threshold17.42011.09843No
